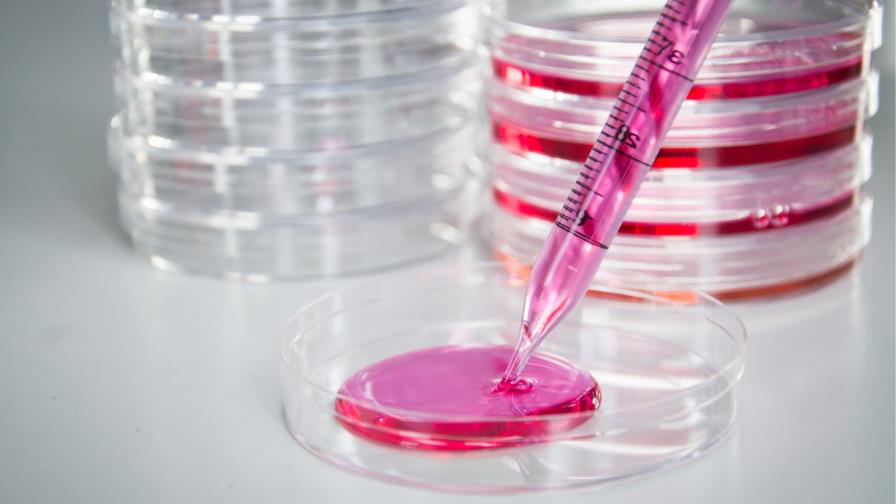
Restauran funciones nerviosas dañadas por el párkinson con células madre

Restauran funciones nerviosas dañadas por el párkinson con células madre
LONDRES. Científicos japoneses demuestran en un trabajo publicado el pasado miércoles en la revista Nature la posibilidad de restaurar funciones nerviosas dañadas por el párkinson gracias al uso de células madre pluripotentes inducidas (iPSCs, en inglés).
A partir de un modelo de la enfermedad en primates, investigadores de la Universidad de Kyoto han logrado mejorar problemas en la movilidad de los animales que sufrían una degeneración neuronal.
El estudio describe la implantación de neuronas dopaminérgicas que transmiten la dopamina derivadas de iPSCs, células adultas que han sido reprogramadas para devolverles la capacidad de diferenciarse en diversos tipos de nuevas células.
El estudio de Jun Takahashi y su grupo es el primer análisis a largo plazo en primates sobre los efectos de la implantación de ese tipo de neuronas en especímenes con párkinson.
El objetivo de esta primera fase de su trabajo es garantizar la seguridad y la utilidad del tratamiento, que en el futuro puede ser sometido a pruebas clínicas en humanos.
El estudio publicado en Nature constata que las células implantadas en los primates sobrevivieron durante largo tiempo, ejecutaron la función dopamínica que se esperaba y contribuyeron a restituir un rango de movimientos que la enfermedad había bloqueado.
Las células derivadas de iPSCs no activaron la formación de tumores cerebrales durante los dos años que duró la prueba, ni dispararon respuestas agresivas del sistema inmunitario.
La cantidad de neuronas dopaminérgicas implantadas que sobrevivieron durante el experimento varió en función de cada animal, lo que ha servido a los investigadores para identificar diversas señales genéticas que podrían afectar a ese proceso.
Los autores del trabajo señalan que es necesario profundizar en la investigación para determinar con mayor precisión cuáles son los marcadores que permiten identificar de antemano las células más aptas para el tratamiento.
En un trabajo paralelo que se publica también el pasado miércoles en Nature Communications, Takahashi y su grupo proponen un método para mejorar la supervivencia de las células derivadas de iPSCs tras su implantación.
Los científicos identifican un grupo de proteínas que juega un papel relevante a la hora de evitar reacciones inmunes negativas y mejorar la supervivencia de las células.
EFE
EFE